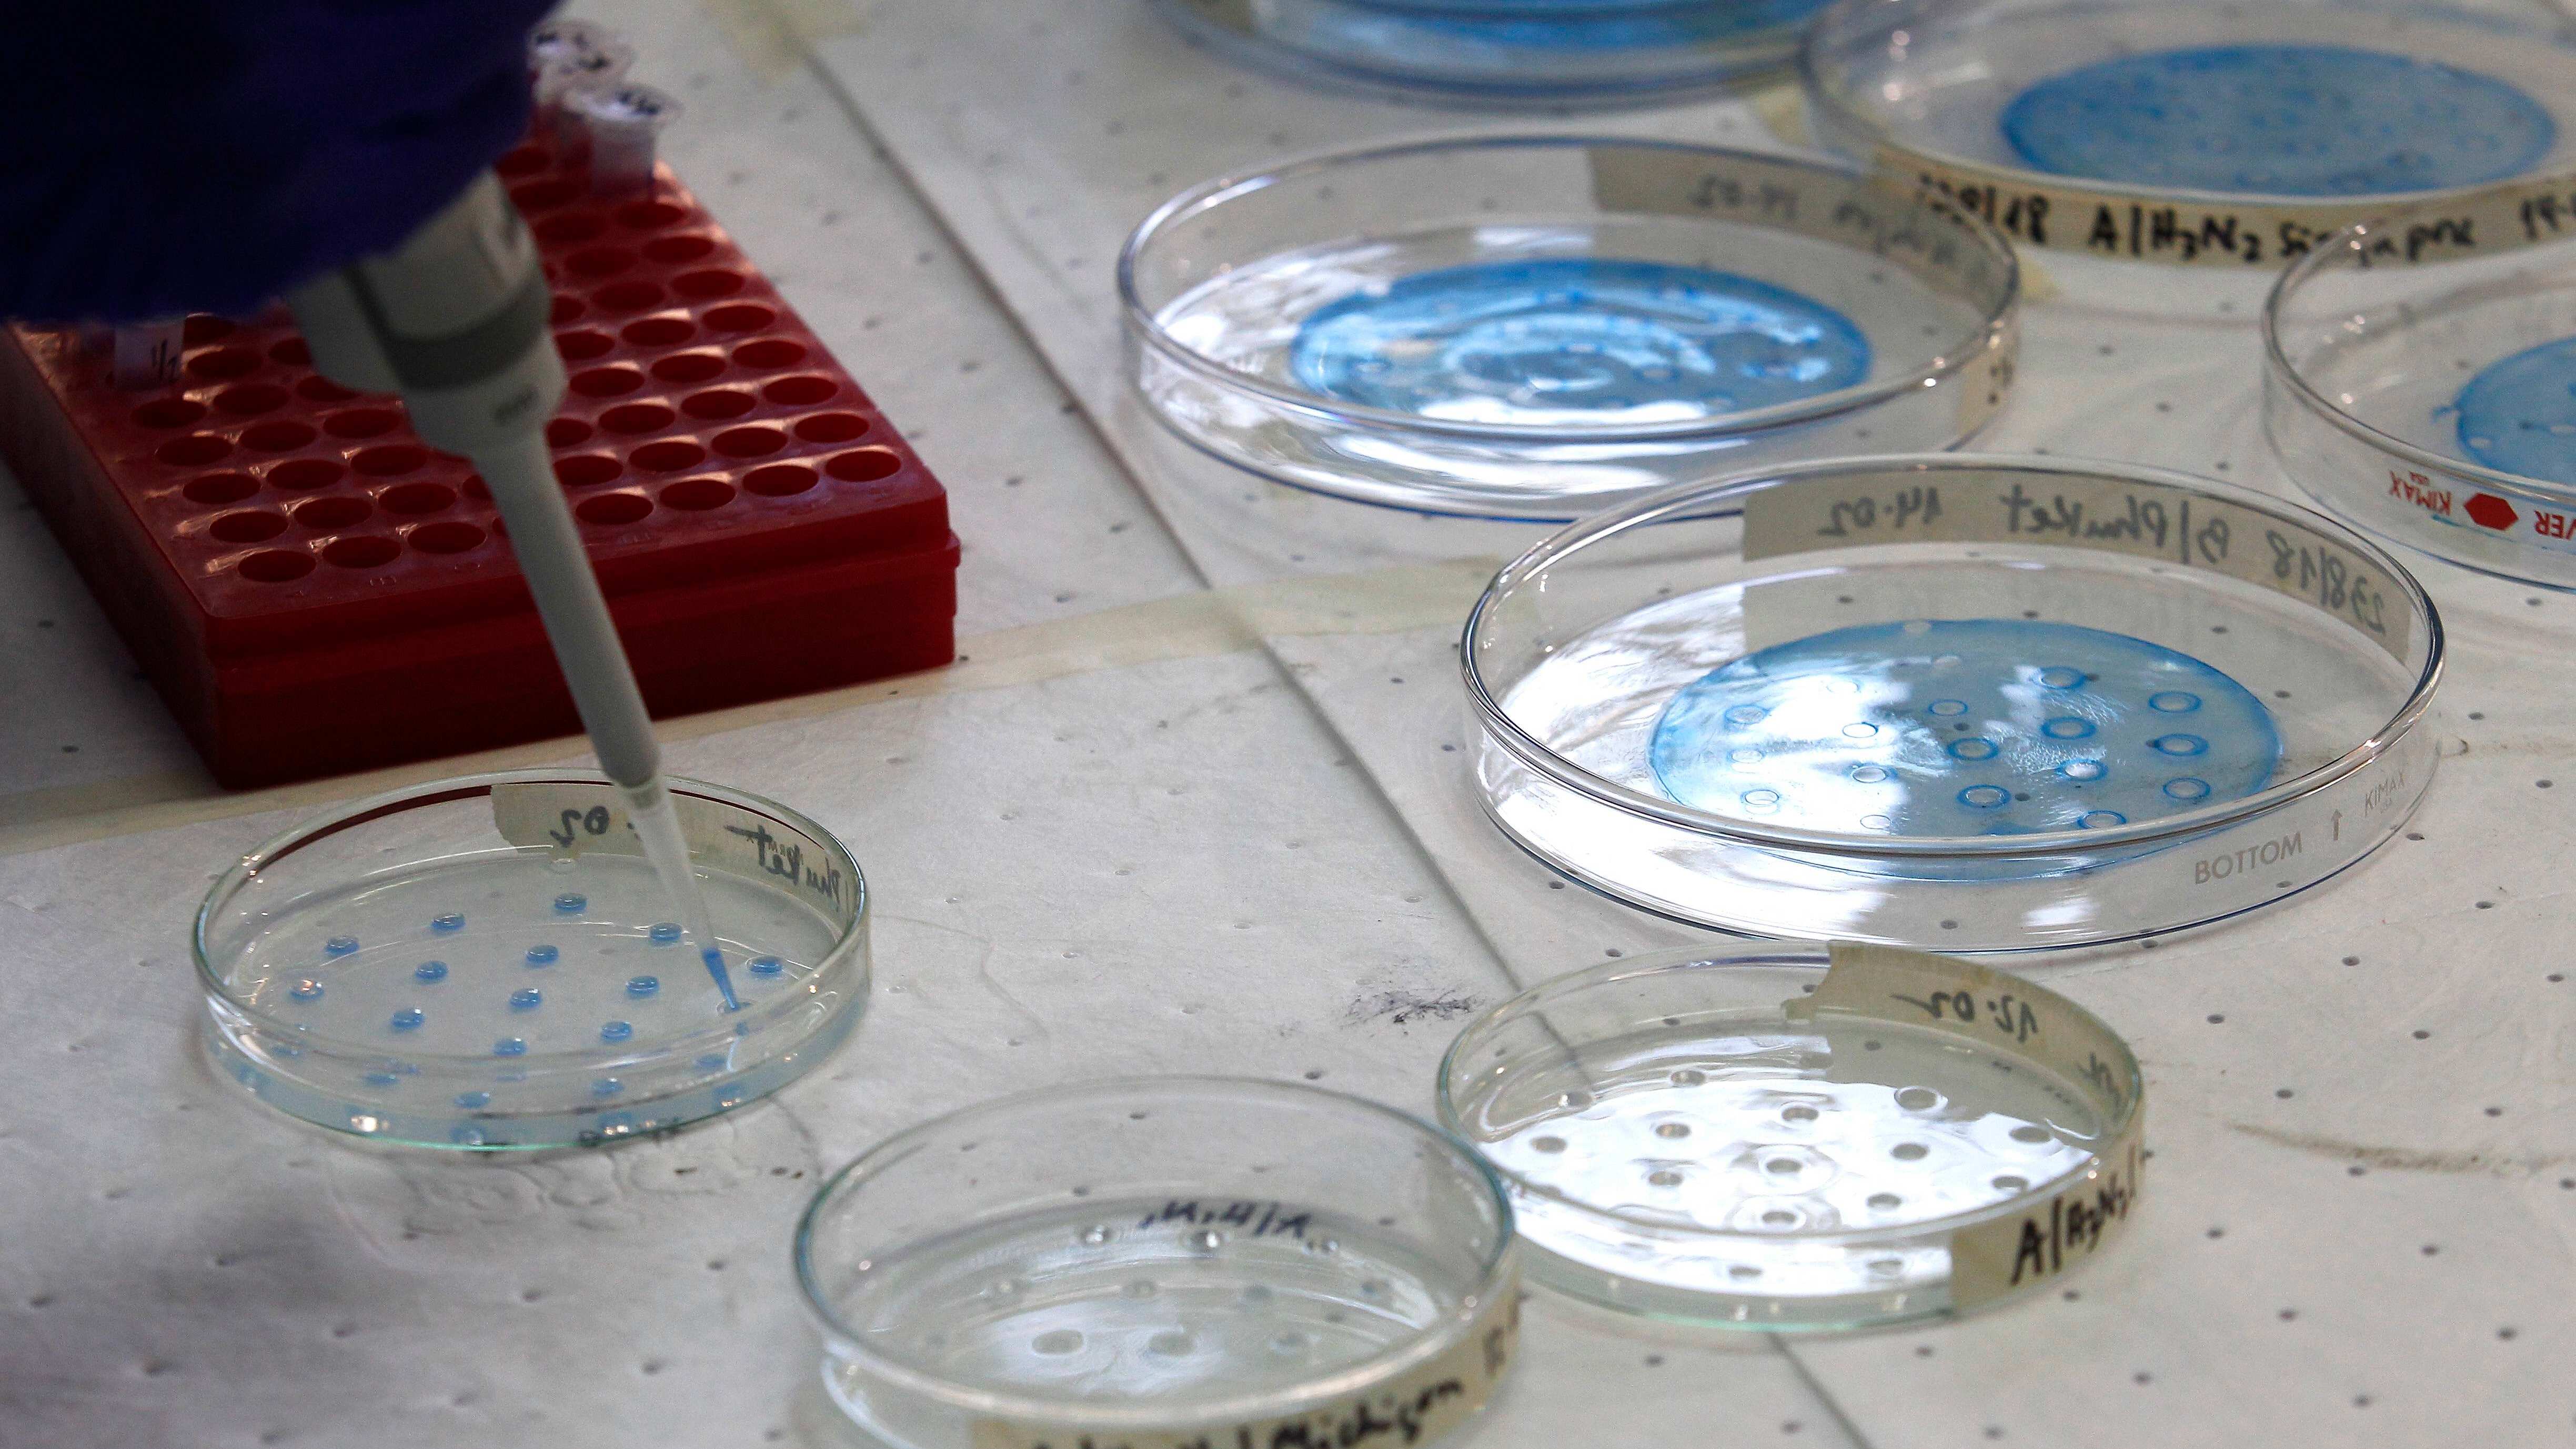

El Ministerio de Salud dio a conocer este lunes un nuevo reporte con los casos de coronavirus en Chile.
El subsecretario de Redes Asistenciales, Arturo Zúñiga, señaló que se reportan 344 nuevos casos de covid-19 en el país, indicando que a la fecha se contabilizan 4.815 casos de covid-19.
Además, informó tres nuevos fallecidos por coronavirus, indicando que las víctimas fatales son de las regiones de Ñuble, Araucanía y Los Lagos, los cuales son pacientes mayores de 60 años.
De esta forma, se contabilizan 37 decesos por covid-19 en el país desde el inicio de la crisis.